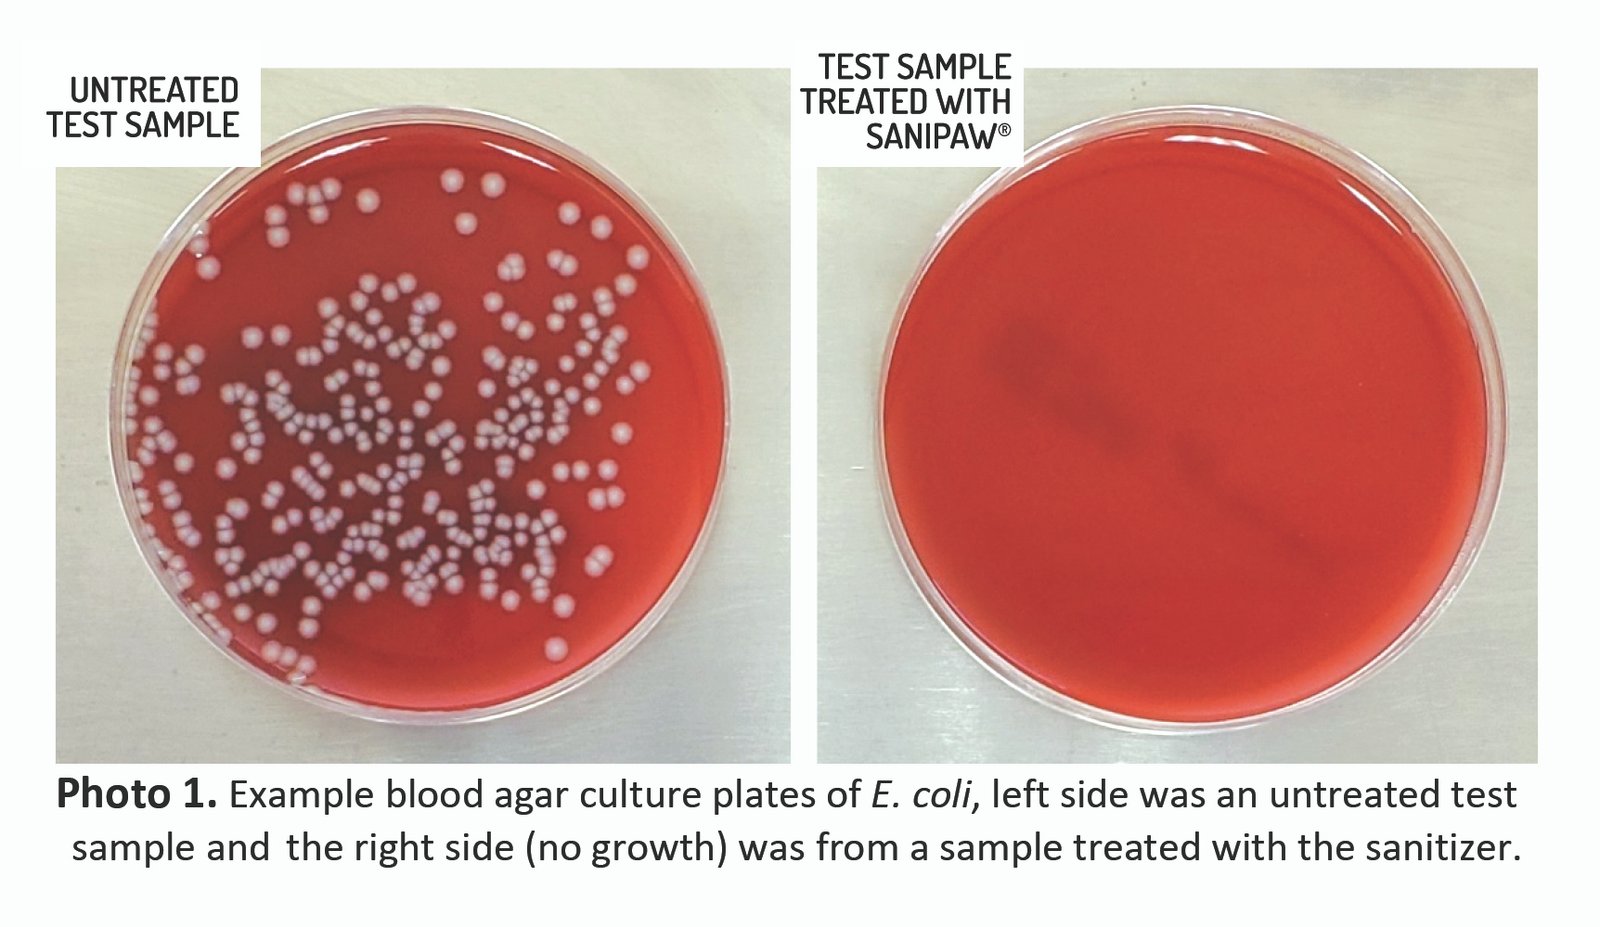

Description
Removes the street from your dog’s feet!™
Dogs step in all sorts of yucky stuff when they’re romping and exploring outside. Fortunately, now you have two grime-fighting tools to protect your home from messy, dirty paws. SaniPaw Spray and Wipes contain a sanitizing agent found in popular mouthwashes that safely eliminates 99.99% of bacteria, virus, fungus and odor on contact. A simple spray or wipe after every walk does it all.

Reviews
There are no reviews yet.